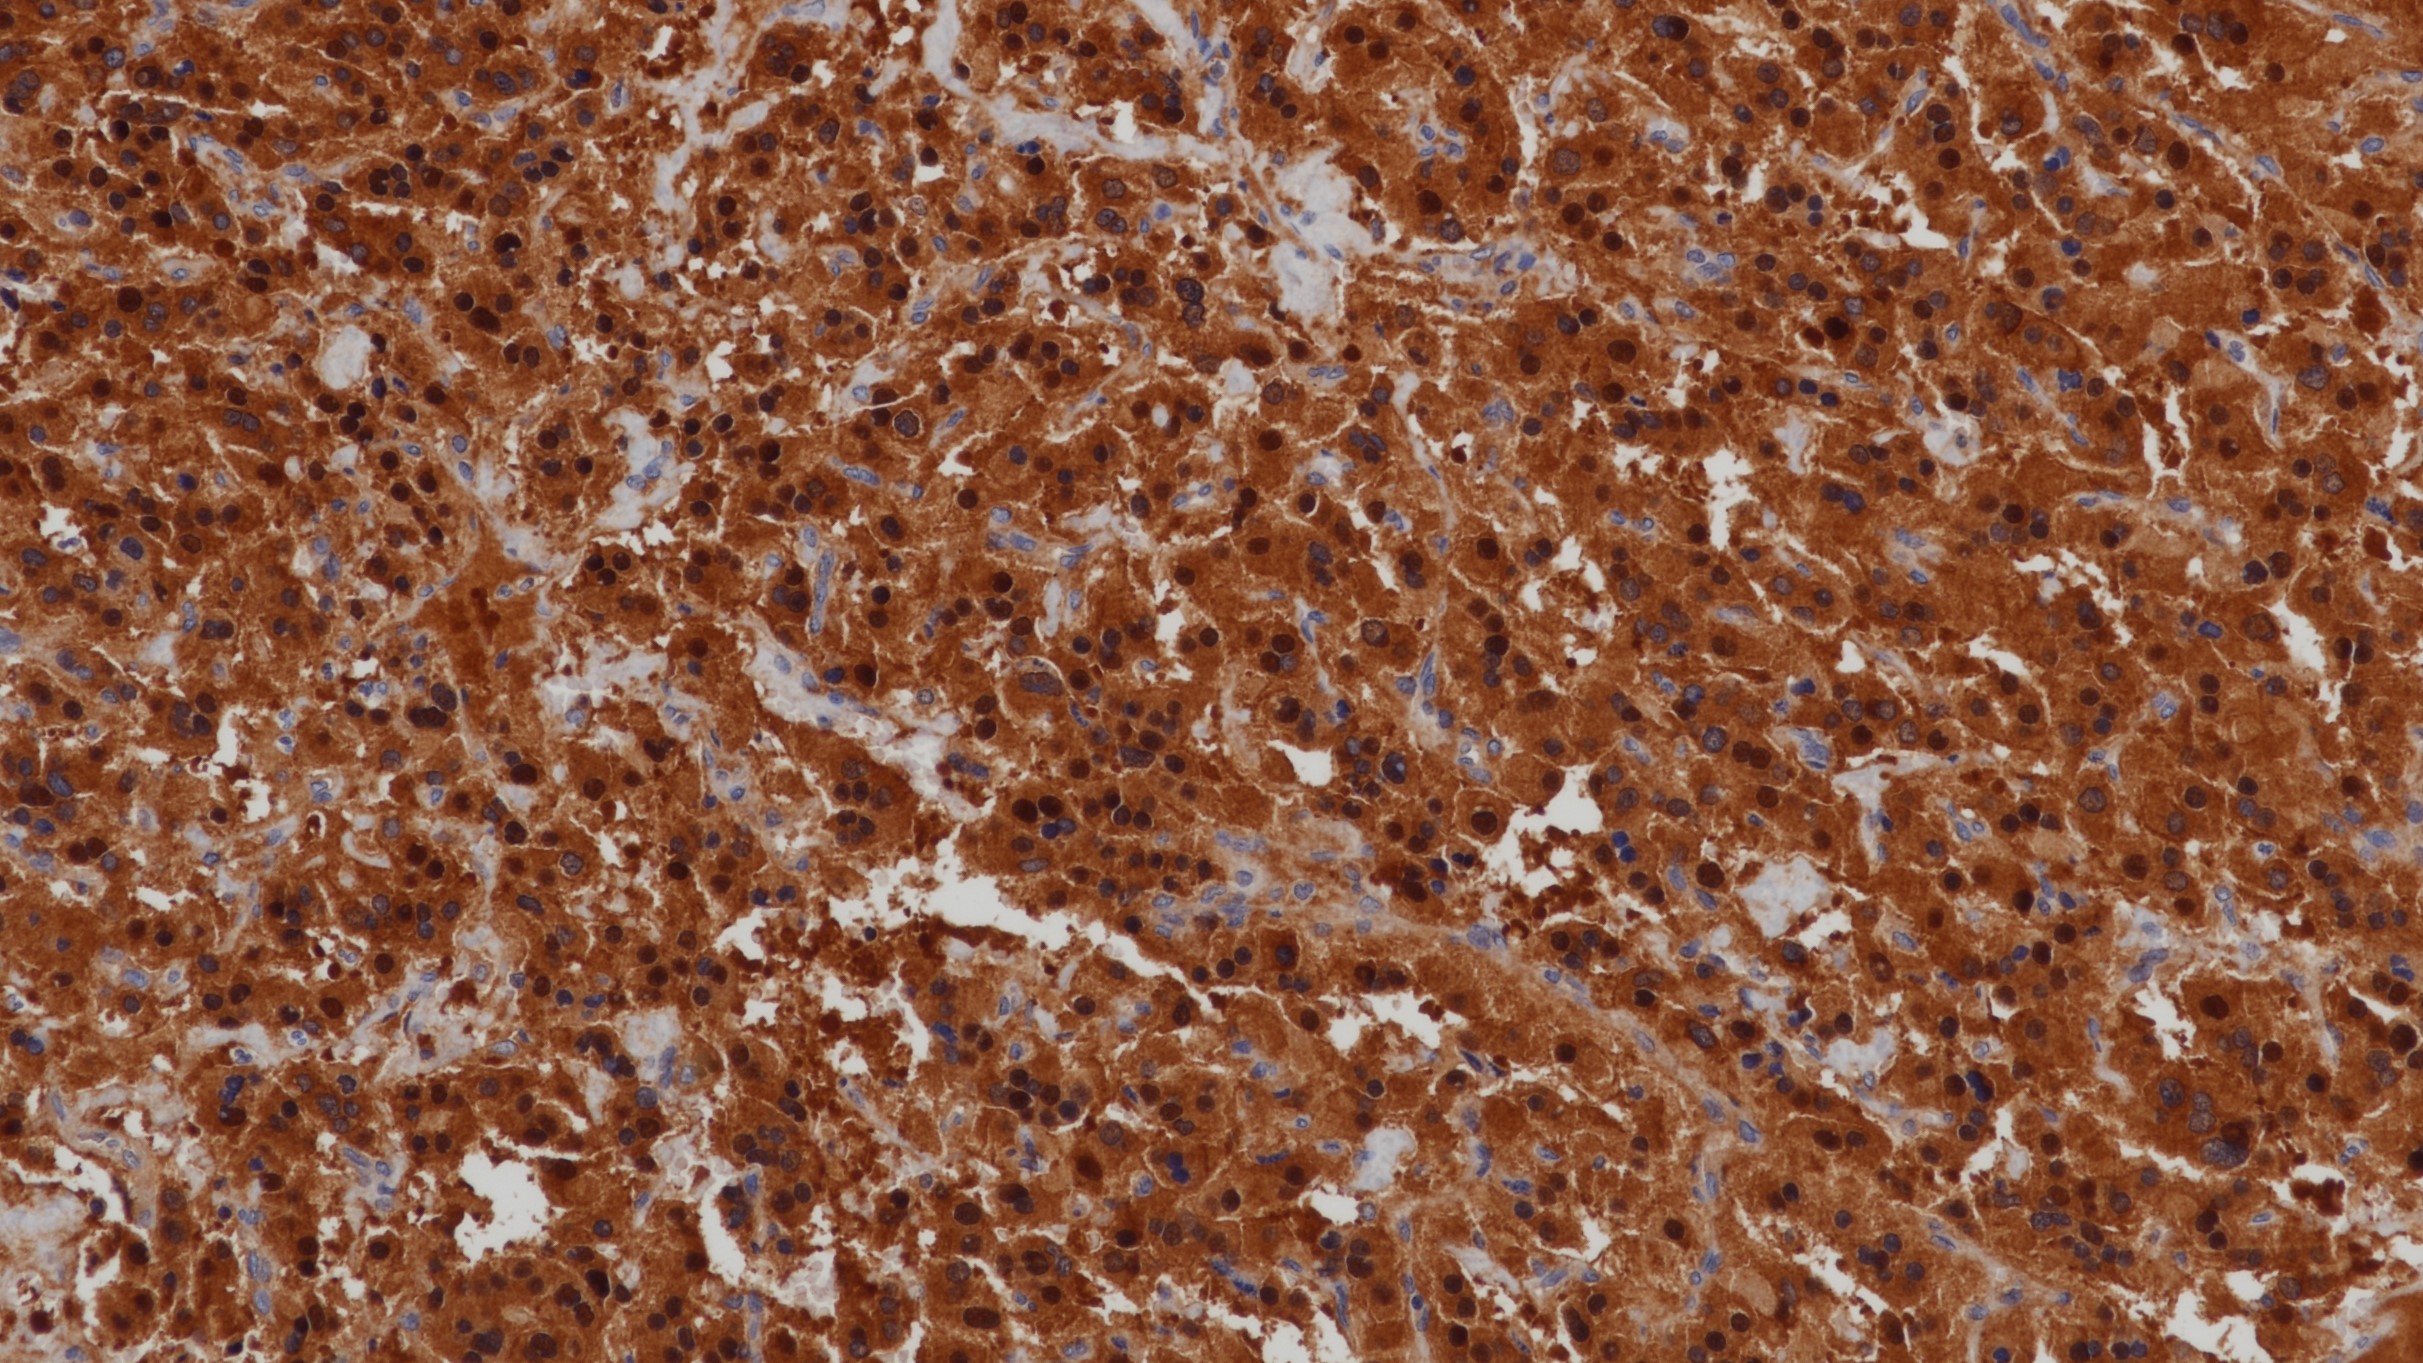
副神经节瘤NSE(BPM6150)染色

1.Glial and neuronal markers in bipolar disorder: A meta-analysis testing S100B and NSE peripheral blood levels[J]. Francesco Bartoli,Błażej Misiak,Cristina Crocamo,Giuseppe Carrà. Progress in Neuropsychopharmacology & Biological Psychiatry
2.Reduced serum levels of neuron specific enolase (NSE) in drug-naïve subjects with major depression and bipolar disorder.[J]. Wiener Carolina David,Jansen Karen,Ghisleni Gabriele,Kaster Manuella Pinto,Souza Luciano Dias de Mattos,Lara Diogo Rizzato,Portela Luiz Valmor,da Silva Ricardo Azevedo,Oses Jean Pierre. Neurochemical research. 2013(7)